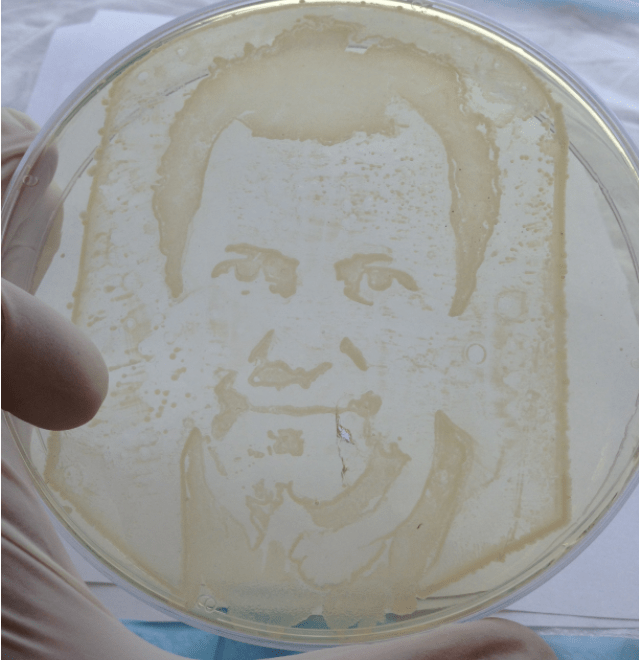
Screen Shot 2016-12-04 at 11.10.01 AM.png

Mobis Artis
Of microbes and machines: how art and science fuse in Bio-art – Sean Redmond and Darrin Sean Verhagen – The Conversation
“There is science in art – the alchemy of paint, the binary codes computing away in a camera, the expressive anatomy in portraiture and sculpture. There is art in science – the artistic precision of the scalpel, the cool aesthetics of the laboratory, and the intimate observations undertaken by scientists to discover new materials and microbes living unseen in the world.”
Morbis Artis: Diseases of the Arts – RMIT University, Melbourne, Australia. November 2016 – February 2017
“Morbis Artis explores the radical conjunction between the biomolecular and the artistic, and the thin doorway between life and death housed within discourses of disease. What constitutes life, what counts as a sentient being, and who gets to determine what lives are saved, punished, exploited and destroyed? Composed of eleven separate but connected installation works, Morbis Artis explores the question of organic life through particular artistic lenses, each taking on the moniker of disease to represent and embody the issues that challenge bare life today.”

Raspberri Pi art: Micro-ritmos
Bacteria sing: Biology Synth Micro-Ritmos. Micro-ritmos is a musical instrument that automatically generates songs based on biology – RaspberryPi – The MagPi Magazin
“Micro-ritmos is a biology musical instrument that automatically generates songs based on the movement of bacteria cells. Raspberry Pi is used to observe the patterns formed in a bacterial cell. Their movements are transformed into audio noises.With Micro-ritmos you can hear bacteria singing. (…) The team behind the Micro-ritmos is Mexican. They are Paloma López, Leslie Garcia and Emmanuel Anguiano. The team is called Interspecfics.”

Installation uses Geobacter bacteria and Raspberry Pi to generate music
Pseudomonas in the shape of New Zealand
Scientists use bacteria to map out NZ – News.com.au
“Producing what looks like a satellite picture at first glance, the Victoria University of Wellington researchers grew green bacteria in the shape of New Zealand’s land mass and blue bacteria to resemble the surrounding ocean. The fascinating image appeared on international science journal Cell Chemical Biology’s front cover and drew attention to the need to engineer better antibiotics.”
Cell Chemical Biology Volume 23, Issue 11– November 2016
“The cover image is a map of New Zealand drawn with pyoverdine-producing P. aeruginosa cells in an ocean of indigoidine-synthesizing E. coli. Cover credit: artwork by Mark Calcott, based on a concept from David Ackerley.”

Cell Chemical Biology Volume 23, Number 11 Issue Cover
On a different note, there is a hilarious website called “World Maps without New Zealand”

“I wonder what that could be”
Vik Muniz
Visual artist Vik Muniz shows ‘continuous invention’, uses of ordinary objects in art – Columbia Chronicle
“During the last Lecture in Photography event of the semester, audience members were able to watch world-renowned visual artist Vik Muniz’s discuss his use of ordinary materials like sugar, chocolate, thread and bacteria to “draw” various subjects. (…) During the Nov. 16 event, Muniz, who has had work displayed in New York City, London and Hong Kong, talked about the meaning of art, his early career as an artist and the multiple series of work he has created.
Vik Muniz’ bacteria portrait – Source: The Creators Project
Ori Elisar: Living Language
Teaching Bacteria to make Living, Evolving Typography – Clara Rodriguez Fernández – Labiotech
“Ori Elisar is an Israeli artist working on Biodesign. His globally-acclaimed project uses bacteria to create living typography that changes over time to represent the evolution of the Hebrew language. The Living Language project uses Paenibacillus vortex bacteria to create living typography. To represent the evolution of the Hebrew language, the artist makes bacteria grow from ancient paleo letter forms to the shapes of the modern alphabet. The experiments were carried out in the microbiology laboratory at Tel Aviv University.”
